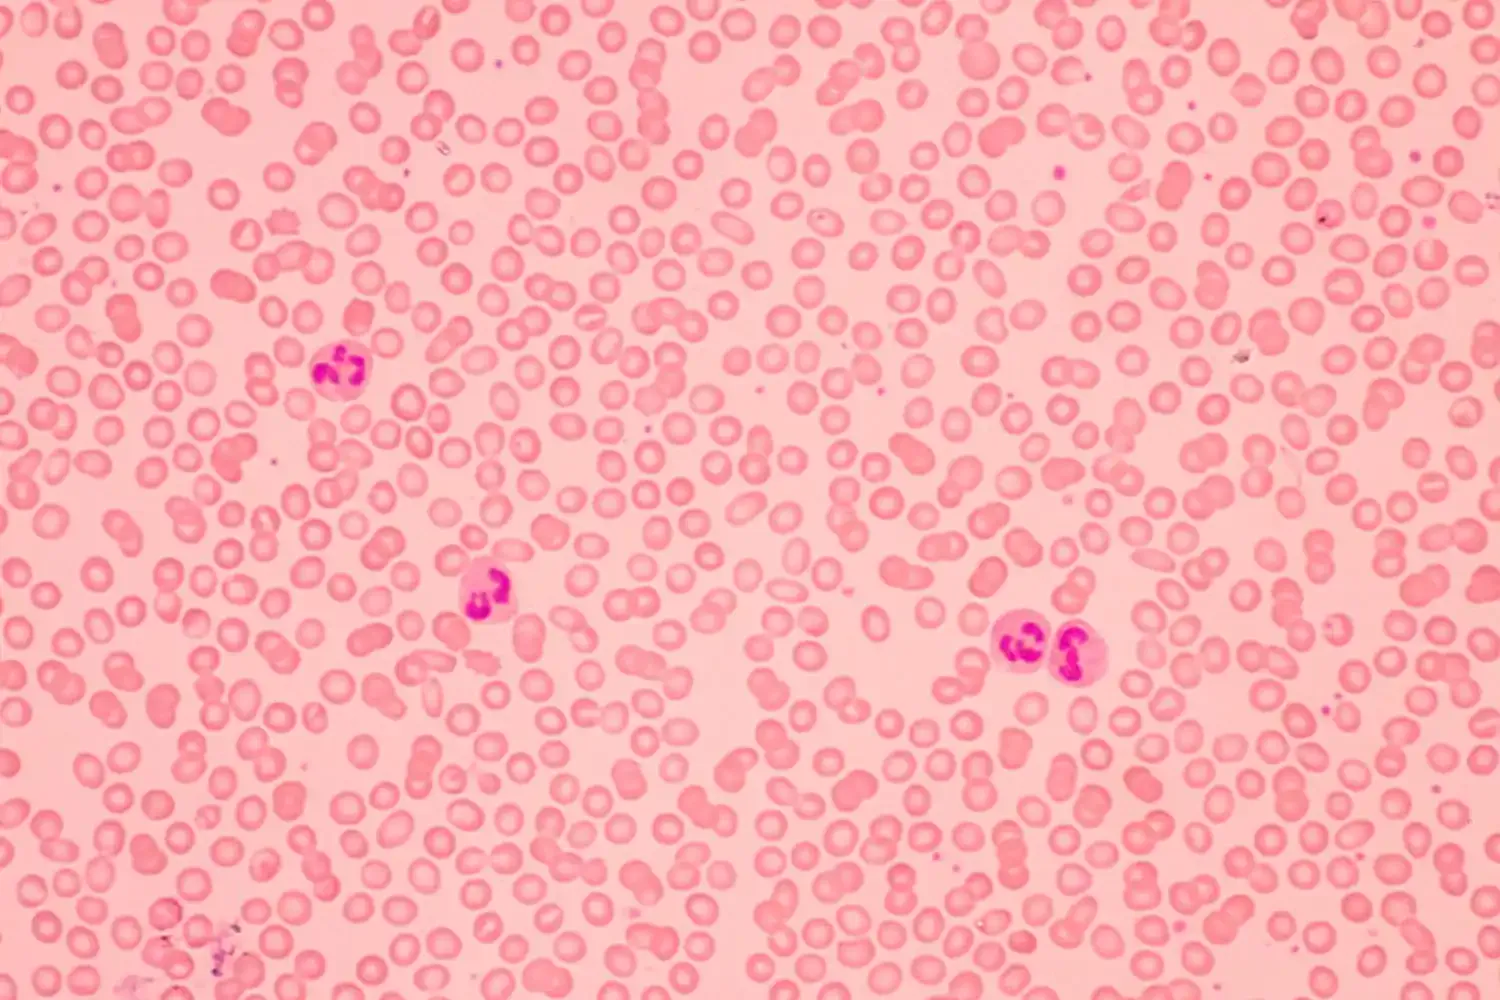
Smart Reader 96孔微板阅读器

数字化手术室的“视觉中枢”
在现代外科手术中,视觉信息的精准度直接关系到手术的成功率与安全性。法国影像专家 i2S 推出的 Ultrasight 系列摄像系统,正是为了解决手术无影灯(Scialytic)环境下极端苛刻的成像需求而生。它不仅是一台摄像机,更是数字化手术室中不可或缺的实时视觉反馈核心。

核心优势:超清、实时、高度定制
Ultrasight 的核心价值在于其极高的灵活性。针对不同医疗机构的预算与技术需求,i2S 提供了从 HD 到 4K 的全方位影像方案。其低延迟的实时视频流确保了主刀医生在操作过程中能够获得瞬时的视觉反馈,这对于微创手术及远程教学至关重要。
“Ultrasight 的意义在于,它将复杂的医疗视觉需求转化为可定制的模块化方案,实现了影像质量与临床效率的完美平衡。”
| 关键参数 | 技术规格 / 选项 |
|---|---|
| 影像分辨率 | 4K Ultra HD / 1080p Full HD |
| 传输模式 | 有线连接 / 无线传输方案 |
| 集成形式 | 整机方案 (Complete Camera) / 核心电路板 (PCBA Sub-assembly) |
| 应用场景 | 手术室无影灯集成、内窥镜辅助、手术示教 |
| 合规性 | 符合医疗级环境标准,支持无菌化设计 |

跨领域延伸:从免疫血液学到生物打印
i2S 的技术积淀并未局限于手术室。基于其深厚的嵌入式视觉功底,该公司在实验室自动化与前沿生物技术领域同样拥有卓越表现。例如,其 Smart Reader 96 孔微板阅读器,已成功集成于全自动免疫血液学分析仪中,用于抗体筛查与分型。
此外,在生物打印(Bio-printing)这一前沿领域,i2S 开发的质量控制显微子系统,能够对生物打印的人体组织进行实时监控,确保细胞排列与组织结构的精确性。这种跨领域的视觉技术迁移,证明了 i2S 在处理复杂生物影像数据方面的强大实力。

结论:医疗影像的端到端交付专家
BookScan 认为,i2S 的核心竞争力不仅在于硬件参数,更在于其“钥匙在手(Turnkey)”的交付模式。从最初的概念设计、原型开发,到大规模量产以及后期的物流维护,i2S 能够陪伴医疗器械制造商走完产品全生命周期。对于追求高性能、高可靠性且需要深度定制的医疗企业而言,Ultrasight 及其背后的 i2S 视觉生态无疑是当前市场的最优选之一。